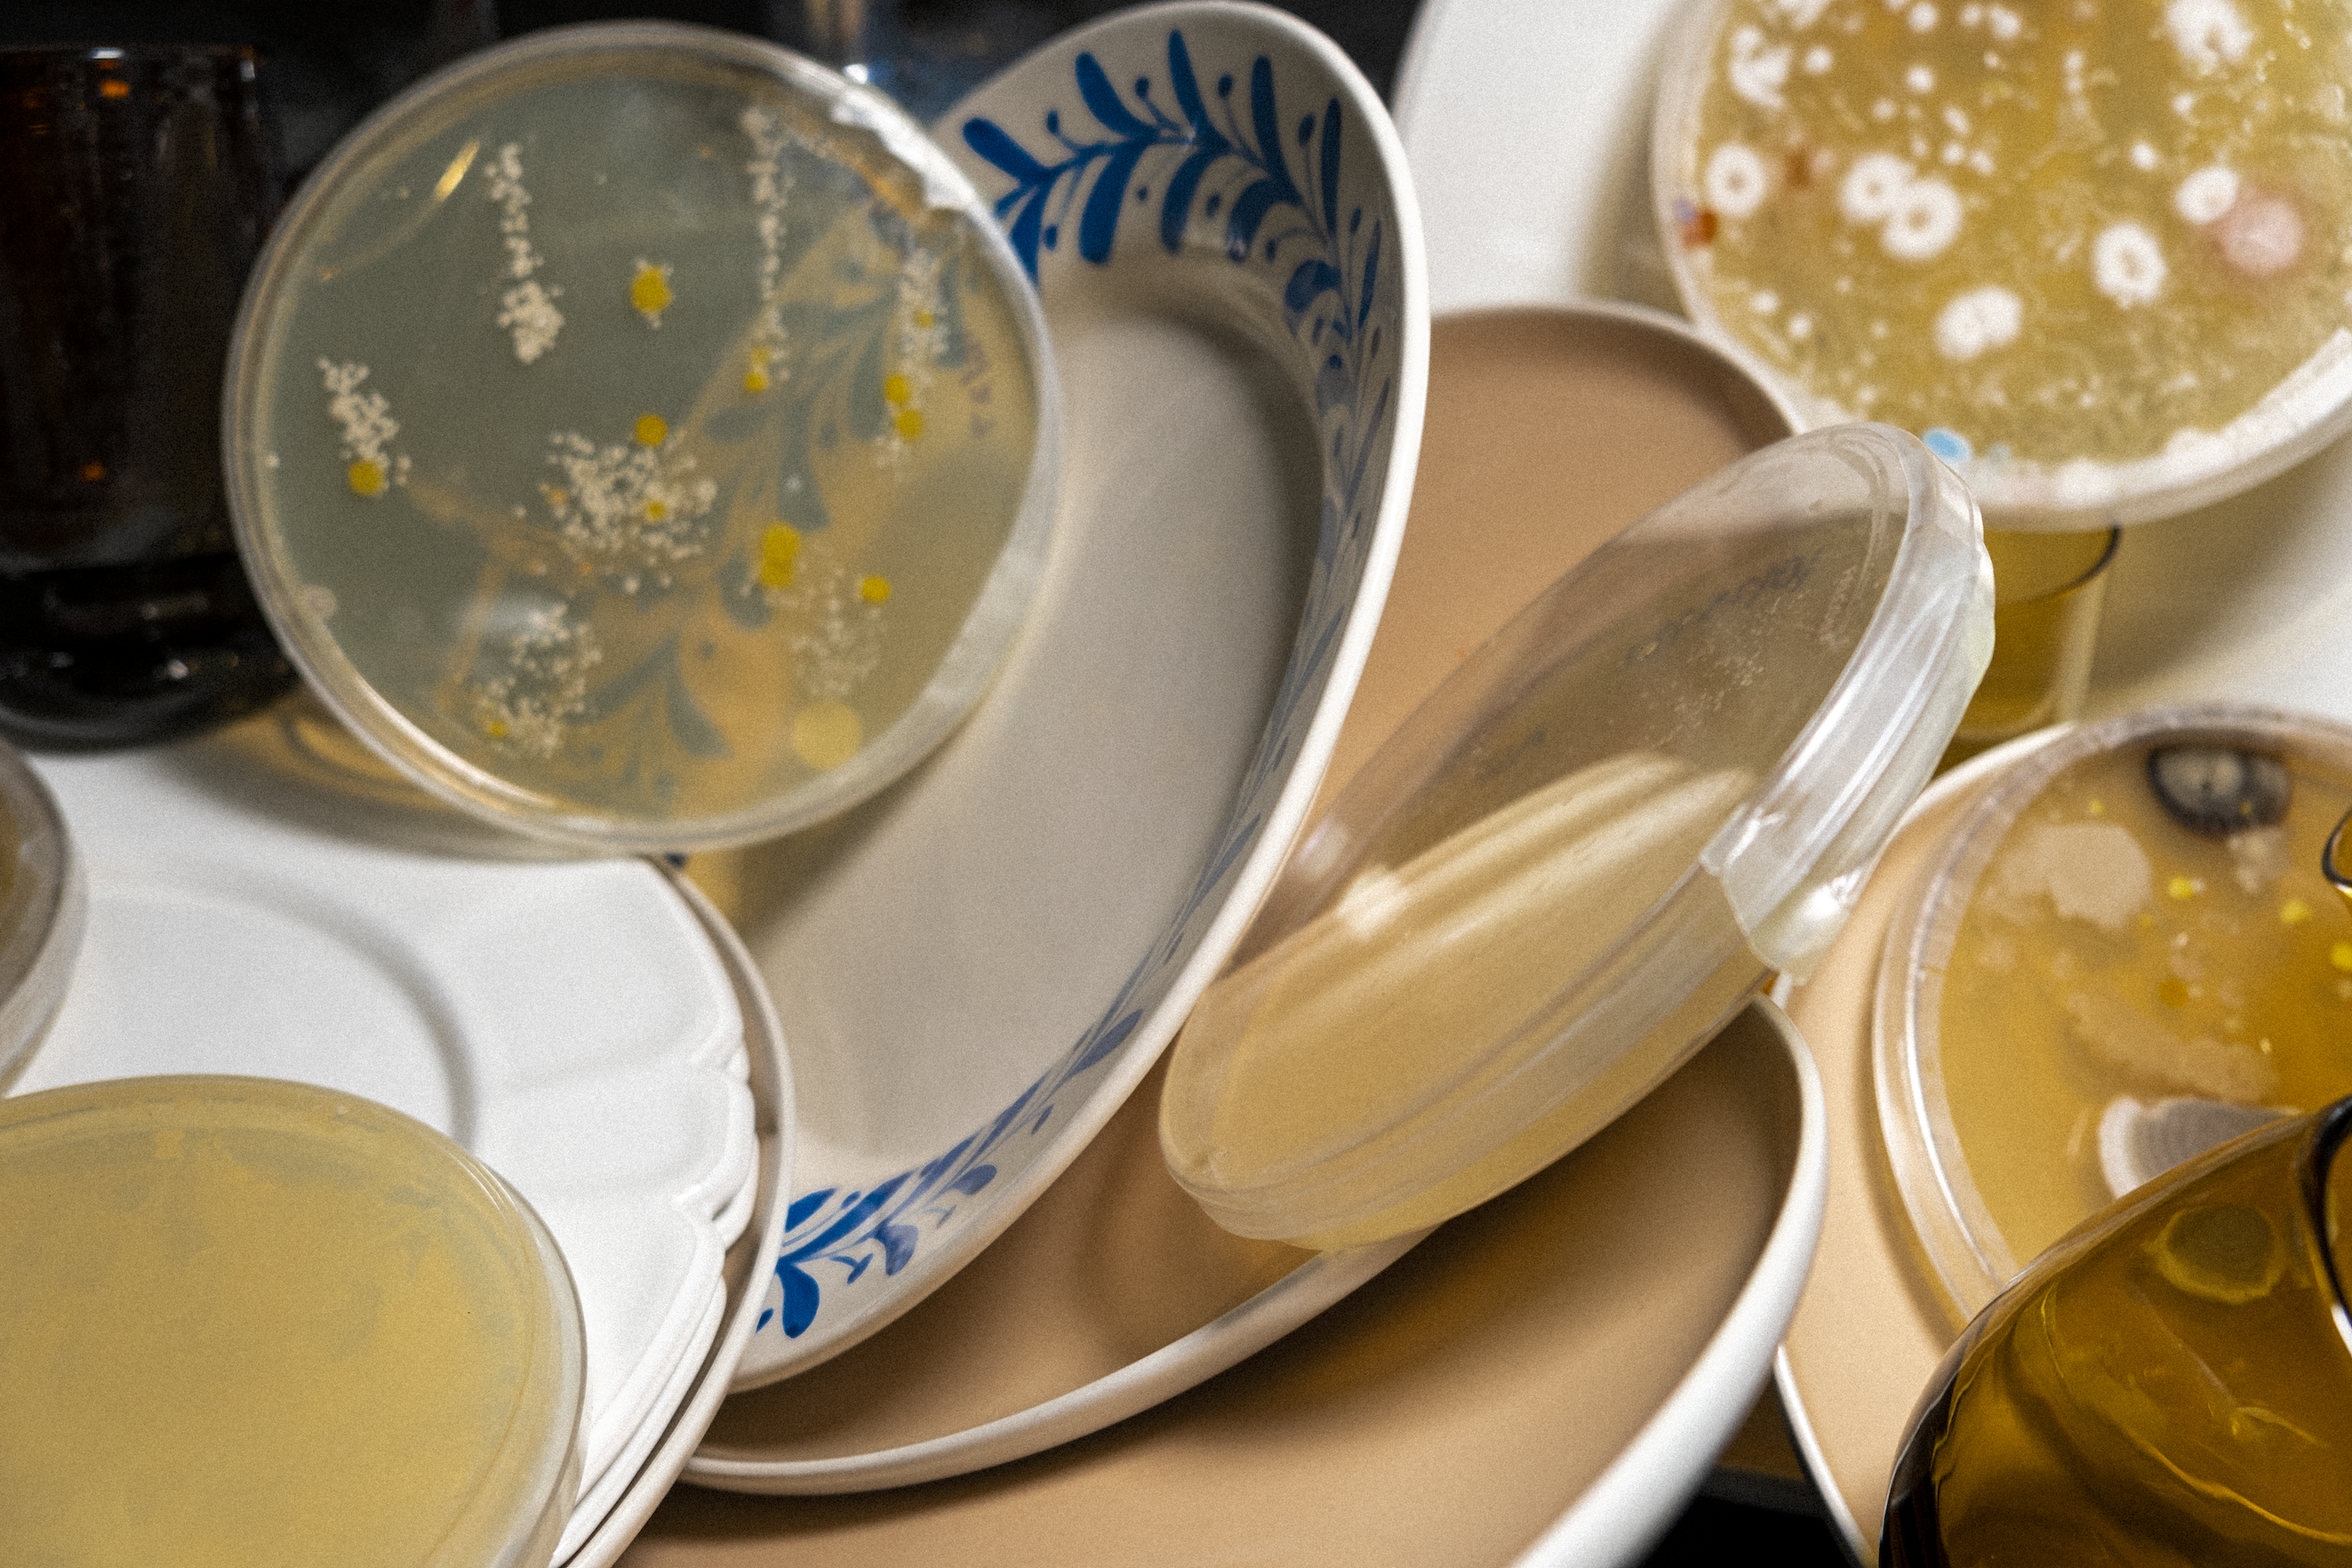

Microbe Kitchen
Microbe
Kitchen is a part of the Bass Connection: Laboratory Arts featuring a
staged photography series of students’ Microbe art samples. Presenting students’
agar art samples from one of the lab sessions in an unconventional way. By integrating laboratory objects into refined dining and
kitchen settings, this undertaking serves as both a commentary on the
transformative influence of environmental context on the interpretation of
objects and a pedagogical example illustrating
the process of expanding a transient laboratory experiment into a more
extensive project.